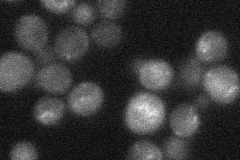
YPL120W
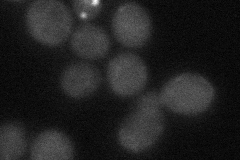
YPL120W

View description
Subunit of phosphatidylinositol (PtdIns) 3-kinase complexes I and II; Complex I is essential in autophagy and Complex II is required for vacuolar protein sorting; ortholog of the higher eukaryotic gene Beclin 1
Localization:
Intensity:
Fold change:
Significance:
-
C’ GFP library in SD

below threshold15.41 -
N' NOP1pr-GFP in SD

cytosol54.4719 -
N' TEF2pr-mCherry in SD

cytosol59.6747 -
N' NATIVEpr-GFP in SD
punctate25.4244 -
N' TEF2pr-VC and Cyto-VN in SD
cytosol29.8133 -
C’ GFP library in SD+DTT

cytosol14.550.94No -
C’ GFP library in SD+H2O2

cytosol13.890.9No -
C’ GFP library in Starvation Media

cytosol24.921.61No -
C’ GFP library on the background of Pup2-DaMP

below threshold -
C’ GFP library on the background of CCT mutant

below threshold14.5350.942626No
